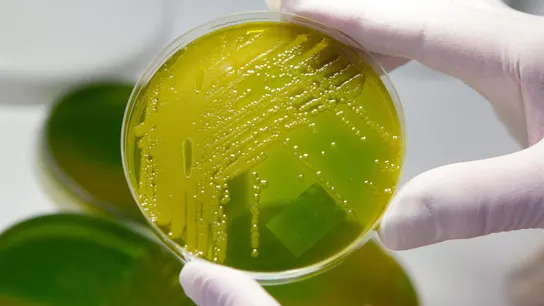

El mundo de la salud

El mundo de la salud

Avance científico

La moda del 'Ny Quil Chicken'

Xenotrasplante en fase de ensayo clínico
De la Universidad de Harvard

Estuvo con él en todo el proceso

En Nueva York

Investigación científica

Irán a más

Premios Nobel 2021

Habla el médico Darío Fernández

La consulta médica, un lugar seguro

Esperanza para los transplantados

Análisis de Olga Mediano

Analiza el caso de las niñas desaparecidas

Hito histórico

Hito sin precedentes

Este martes 25 hay convocada una manifestación